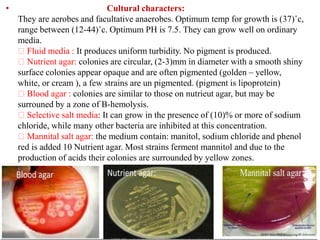
• Cultural characters:
They are aerobes and facultative anaerobes. Optimum temp for growth is (37)˚c,
range between (12-44)˚c. Optimum PH is 7.5. They can grow well on ordinary
media.
Fluid media : It produces uniform turbidity. No pigment is produced.
Nutrient agar: colonies are circular, (2-3)mm in diameter with a smooth shiny
surface colonies appear opaque and are often pigmented (golden – yellow,
white, or cream ), a few strains are un pigmented. (pigment is lipoprotein)
Blood agar : colonies are similar to those on nutrieut agar, but may be
surrouned by a zone of B-hemolysis.
Selective salt media: It can grow in the presence of (10)% or more of sodium
chloride, while many other bacteria are inhibited at this concentration.
Mannital salt agar: the medium contain: manitol, sodium chloride and phenol
red is added 10 Nutrient agar. Most strains ferment mannitol and due to the
production of acids their colonies are surrounded by yellow zones.

This document discusses the classification and typing of bacteria. It begins by explaining that bacteria can be grouped using phenotypic typing schemes utilized by clinicians, which examine bacterial morphology, staining properties, oxygen requirements, and biochemical tests. It also notes the importance of identifying the environmental reservoir and transmission means for clinicians. The document then provides details on various classification schemes for bacteria, including based on shape, staining, oxygen requirements, temperature tolerance, and structure. It focuses on the Gram stain technique and discusses characteristics of Gram-positive and Gram-negative bacteria.